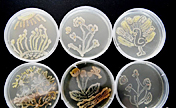
???? ?????? ?????? "??????? ?????????"

|
| ??????? ??????? ????? "??????? ?????????" ???? ?? ????? 2019 |
????? ?????? : ?. ?????
5 ????? 2019/????? ????? ??????? ???????/"??????? ?????????".. ???? ???? ??? ????? ??????? ?????? ???????? ?????? ???????? ?????? ????? ?????? (Alstom)???? ??? ?? ?????? ????????? 25 ???? ????? ???? ???? ?????? ??? ????? ?????? ????? ??????. ??? ??? ??? ??????? ??????? ?????? ???? ???? ?? ????? 2019 ??? ?????? ?? ?????? ????? ??? ????? ?????????? ???? ?????? ???????? ??????? ??? ??????? ??????? ???????? ??? ???? ??????? ???????. ????? ???? ????? ???????? ??? ??????? ?????? ???? ??????? ???????? ??????? ???? ???????? ????????? ???? ????? ????? ??????? ??????? ????? ?????? ?????? ?? ?????? ????? ???? ?????? ???????? ???????? ?????.

????? ?????? .. ?????? ?????
??? ?????? ???????? ???? ???? "??????? ?????????" ?? ???????? ??????? ????? ???? ??????????? ????? ??????? ??? ?? ???? ???? ??? ????? ???????? ???? ???? ??????????? ???????? ???? ???? ????? ??????? ??? ???? ??????????? ?????????? ?????????? ??? ??? ???????? ??????? ????. ?????? ??? ?? ???????? ??????? ?? ????? ?????? ????? ???? " ??????? ???????? ???????? ?????? ????????" ? ????? ??? ??? ??????? ?? ??? 1977? ??? ???? ??? ???? 25 ?????? ????? ??? ??????? ?? ????? ??? ?????? ??????? ????????? ???? ???? ????? ?? ??????? ??? ?????????? ?????? ????? ??????? ????? ??????? ???? ?????? ?????????? ??? ????? ??????? ????????? ?? ??? ???? ?? ?????? ?? ????? ??????? ??? ????????? ????? ?????? ??????? ???????? ?? ????????? ??????? ?????? ?????????? ???? ??????? ????? ???????? ???????. ?????? ?? ?? ?????? ??????? ????????? ?????? ????? ?????? ??? ?? ??? ??????? ???????? ??? ????????? ????????? ?????? ???????? ???? ??????? ?? ??????? ??? ???????? ???? ??????? ???????? ??? ??????? ??? ????????? ???? ?????? ??? ???????. ???? ?? ???? ????? ???????? ??????? ??? ??????? ????????? ??? ????? ??????? ???? ?????? ????????? ?? ??? 1998? ???? ?????? ??? ????? ??????? ????????? ???????? ?????? ??? ??? ?????? ?????? ?????? ??? ??????? ?? ????? ???????? ?? ???? ??? "??????? ????? ??????? ????????? ???????? ??????? ??????" ???? ?????? ?? ????? ??? 1997. ???????? ??? ???? ?????? ?????????? ?? ??? 2005 "????? ??????? ????????" ?????? ????? ?????? ??? ???????? ????? ????? ????? ??????? ???????? ?????? ?????? ?? ?????? ??????? ????????? ?????? ??????? ????????? ??? ??? 2005.
??? ???? ??? ??? ??? 2005? ???? " ??????? ???????? ???????? ?????? ????????" ???? ?? 100 ????? ???? ?? ????????? 60? ?? ??????? ???? ??? ???????? ?? ????? ???????? 15? ??? ?? ??????? ?????????. ?????? ??????? ?? ??? ??????? ?????? ??????? ????????? ???? ?????? ???? ???????? ?? ??? 2010? ???? ??????? ???????? ????? ??? ??????? ?? ?????? 14 ????? ????? ?? ???????? ??????? ?????????? ??? ?? ?????? ???????? ??? ?????? ??????? ???????? ????? ?? ?????? ??????? ???????? ?????:" ?? ??? ?? ????? ?????? ?? ??? ??? ????? ??????? ????? ?? ????? ??????? ?????."

??????? ????????? .. ???? ????? ????? ?????????? ?????????
??? ?????? ???????? ??? ???? ???? ???? ?? ???????? ???????? ??? ?????? ??????? ???? ???? ?????? ????? ????? " ??????? ???????? ???????? ?????? ????????"? ????? ?? ?????? ?? ??????? ????? ????? ??????? ?????????? ??? ?????? ???? ??? ?????? ??????? ??? ?????????? ?????? ??????? ??? ??? ???? ????????? ???????? ??????? ???? ?? ???????? ???????? ??? ????? ??????? ?????? ???????????? ????? ???? ??????? ???????? ???????? ??????? ? ????? ?? ?????. ?? ??????? ?????? ????? ????? ????????? ?? ??? ???? ?????? ?????? ??????????? ????? ???????? ??????? ??????? ?"??????? ???????? ???????? ?????? ????????" ????? ???. ????? ??? ?? ??????? ??????? ???? ??? ????? ????? ????????? ?????? ?? ?????? ???????.
???? ??????? ??????? ????????? ???? ??????? ???? ??????? ??? ?? ??? 2014? ?? ??? ????? ????? ??????? ???? ????? ??????? ????? ??????? ???? ???????? ?????? ???? ????? ???????? ??? ????? ??? ??????? ?? ???? ????? ??????? ?????? ?? ??????? ??????? ???????? ?? ??? 2018? ???? ??? ?? ?????? ?????? ??????? ?? ???????? ???? ?? 500 ??? ???? ?? ?????? ????? ??????? ????????? ?????? ????????? ???????? ??? ? ???? ??? ??? ????????? ???? ?????? ?? ??? ????? ??????? ?????????? ???????? ?????? ????? ?????????? ??? ???? ???? ??? ?????? ?????? ??????? ????? ???? ????????? ?????. ???? ??????? ?? ?? ??? ???? ?? ??? ?????? ???????? ???? ????? ?? ???? ?? ?? ?????? ?????:" ??? ?????? ????? ?? ?? ??? ????????? ?????." ?????? ?? ???? ???? ??? ?????? ???????? ???? ???? ?? ???? ?????? ???????? ????? ??????? ???????? ??? ????? ??????? ???????? ??? ???? ??? ?????? ?? ??? ?????? ?? ?????? ?? ???? ????? ?????? ?? ????? ??????? ??? ???? ??????? ?? ?????? ????????? ?????? ?? ???? ?? ??? ?????? ?? ??????? ????? ??? ???? ??? ????? ?????? ??????? ????? ?????? ?? ??? ????? ????? ????? ????? ??? ??? ????? ??? ????? ???? ????? ??????? ?? ?????? ????? ???? ??????????? ????????? ?????? ???? ????? ???? ??? ????? ???? ?????????? ???????? ?? ???????? ???? ??? ??? ??? 2013 ??????? ???? ???? ???? ????? ??????? ?????? ?? ??? ????? ????? ???? ??? ????????? ??? ???? ??????.

?????? ???????? .. ??? ??????? ????????? ?? ????? ??????????
??? ??????? ??? ?????? ?? ?????? ????????:" ????????? ???????? ?? ??????? ????????? ??????? ???? ????? ?? ?????? ???? ????? ??? ?????? ??????? ???? ?? ??????? ?? ?????? ???? ???? ??? ????? ???? ???? ???? ????? ?????? ????? ????????? ?? ???? ??? ????? ??? ????? ???? ??????? ????? ???? 9 ????? ??? 10 ????? ?????? ???????? ??????? ??? ?? ?? ??? ????? ?? ???? ??? ???? ????? ???? ????? ??? ????? ?? ???." ??????? ??????? ???? ??????? ?????:"??? ???? ?? ???????? ????? ?? ????? ????? ?? ??? ?????? ??? ???? ?? ?????? ?? ??????? ?????? ??? ??? ???????? ??????? ?????????. ??? ????? ??? 2013? ??????? ?? ??? ???? ????????? ???????? ???????? ?? ???? ?????? ???????. ??? ????? ????? ??? ??????? ????? ??? ???? ????? ??????? ???????? ???? ??? ?????? ??? ??? ????? ?? ?????? 2012? ?????? ?? ???? ????? ??? ??? ?? ???? ?????? ????? ??? ????? ????? ????? ???? ??: "????? ???????? ??? ?? ??????? ??? ??? ????? ????? ???? ??? ???? ?????? ???? ?????? ?????? ?? ???? ?????? ???????? ??????? ???????? ???????? ??? ????? ???? ?????? ????? ??? ????? ???? ?????? ??? ????? ??? ???? ?????? ??? ????? ????? ??? ". ???? ???? ?? ?????? ?? ????????? ????????. ?????? ??? ?? ??????? ??? ?????? ????? ?????? ??? ????? ????? ???? ??? ?????? ????? ??? ??????? ???????? ????????? ??? ????????? ???????? ??? ??????? ???? ??? ??? ?????? ?????? ?? ???? ??????? ???? ?? ??????? ???????? ?? ???????? ??? ???????? ?? ??????? ??? ??? ???? ?? ???? ??? ?????? ???? ??????." ?????:" ????? ?????? ?????? ???? ???? ???? ??? ???????? ??????? ?? ?????? ??? ????? ??????? ????? ????? ??? ??? ?? ??? ????? ????? ??????? ??? ??? ???? ?????? ?? ??? ???? ??? ?????? ??? ??????? ?????? ?? ???????? ??????? ??? ????? ?? ??????? ???? ?????? ????? (?????? ?????? ?????? ?????? ??????? ???????)? ???? ????? ??? 50 ????? ????? ???? ?? ?????? ??? ??????? ????? ??????? ??? ?? ????? ??????? ??? ???? ??????? ??? ????? ????? ??????? ??????? ??? ??? ???? ?????? ?????? ???? ??????? ??????? ????? ??? ?????? ??? ??????? ??????? ?????? ???? ???? ??????? ??? ???? ???? ?? 50 ????? ?? ?????? ???????? ?????? ????? ??? ??? ??? ???? ?????? ?? ?????? ??????...??? ?????? ?????? ???? ??????? ??? ????? ????." ??? ???? ??????? ??? ?????? ?? ????????? ?? ??????? ???????? ????????? ??????? ?? ???? " ??????? ?????????"? ??? ??? ?? ?????? ?????? ????? ?????? ???? 9 ????? ??? ?????? ??? ?????? ??? ??????? ????? ???? ???? ???? ???? 14 ?????? ??? ????? ??? ????? ???? ?? ??? ?? ??? ??????? ?? ??? ???? ??? ???????? ?? ?????. ??? ??? ?????? ????? ????? ???? ??? ???? ??????? ??????? ???? ???? ???? ?? ???????? ??? ???? ???? ???? ????? ??????.
????? ?????????? ????????? .. ????? ????????
???? ??????? ??? ?? ?????? ?????? ??????? ???????? ?? ??????? ??????? ????? ???? ?? ?? ???? ??? ??????? ???????? ??? ????? ?? ????? ???????? ???????? ?????? ??????? ???????? ?????? ??? ????? ?????? ????? ?????. ??? ????? ??????? ?? ?????? ??????? ???? ??? ?? ?????? ?? ????? ???????? ??????? ????? ?????? ??????? ????? ???. ??? ????? ?????? ?????? ????? ?? ???? ??????? ????????? ????? ??? ???? ??????? ??? ?????. ???? ????? ????? ??????? ?? ??? ???????? ??????? ???? ????? ??????? ????????? ??????? ????? ?????? ?? ??????? ????????? ???? ???? ???? ???? 15 ????? ?????? ?? ?? ??????? ????????? ??????? ?????? ??????? ?????? ?? ????? ?????? ????? ??????. ????? ??????? ??? ?? ???????? ??????? ??????? ????? ??????? ?????? ??? ??????? ??? ???????? ???????? ??????? ??? ???????? ?????? ???? ???? ?????? ???????.
?????? ??????? ??? ?? ???? ?????? ????? ???? ????? ???? ?? ?? ??? ?????? ???? ?????? ??? ???? ??? ??? ??????? ?????. ??? ?????? ?????? ?????? ?? ???????? ???????? ???? ????????? ?? ?????? ?? ???? ???? ????? ????? ?????? ??????? ???????? ?????? ?? ???????? ???????? ??? ???? ??????? ?????? ???????? ?????? ????????? ???. ????? ?? ????? ?? ?????? ???? ????? ????? ??? ????? ?? ??? ??????? ??? ?? ?? ???????? ?? ??????? ???? ?? ???? ??? ????? ???? ???? ??????? ????? ????? ???????? ???????? ??? ????? ???? ??????? ????? ??????? ???????? ?? ?????? ????? ?? ?????? ??????? ????????? ???????? ??? ????? ??????? ?? ???? ????? ??????? ?????? ?? ??????? ??? ??????? ????????? ???? ??? ??????? ???????? ?????????? ??? ???? ??????? ????? ????? ???? ?????? ??? ????? ???? ??????? ???????? ????? ??? ?? ??????? ???? ????? ???????? ???????? ???????? ???????? ?????? ????????? ????? ?????? ??? ????? ?????? ????? ???? ??????? ??? ??? ??? ????? ??? ????? ?????? ????? ???????? ???????? ????????? .
 ??? ???? ????? ????? ????? ??????
??? ???? ????? ????? ????? ?????? ????? ?????? ?? ???? ????? ???????? ??????? ???70 ?????? ????? ???????
????? ?????? ?? ???? ????? ???????? ??????? ???70 ?????? ????? ??????? ???????? ?????? ???? ??? ??????? ???????
???????? ?????? ???? ??? ??????? ??????? ?????? ???? ???????? ???????? ?????? ???????
?????? ???? ???????? ???????? ?????? ??????? ????? ???? ?? ????? ????????... ???? ????? ?????? ?????? ?????
????? ???? ?? ????? ????????... ???? ????? ?????? ?????? ????? ??? ??????: "?????" ?? ???? ???????
??? ??????: "?????" ?? ???? ??????? ???? ?????? ?????? "??????? ?????????"
???? ?????? ?????? "??????? ?????????" ???? ??????? ??????? ??????? ?? ???????
???? ??????? ??????? ??????? ?? ??????? ?????? ???? ??? ??? ????????? ?? ???? ??? ?????
?????? ???? ??? ??? ????????? ?? ???? ??? ????? ??????: ????? ????? ?????? ??? ??? ?? ?????? ?????? ??????
??????: ????? ????? ?????? ??? ??? ?? ?????? ?????? ?????? ???? ???? ???? ????? ?????? ???? ???? ????? ?? ???????
???? ???? ???? ????? ?????? ???? ???? ????? ?? ??????? ???? "??????? ????????" ?? ??? ??? ??????? ???? ??????
???? "??????? ????????" ?? ??? ??? ??????? ???? ?????? ????? ???? ?? ??????? ???????? ????? ????? ?? ????? ???????
????? ???? ?? ??????? ???????? ????? ????? ?? ????? ??????? "????? ????????": ??? ????? ???? ?????? ??? ????
"????? ????????": ??? ????? ???? ?????? ??? ???? ??????: ???? ????? ????? ??? "???? ???????"
??????: ???? ????? ????? ??? "???? ???????"